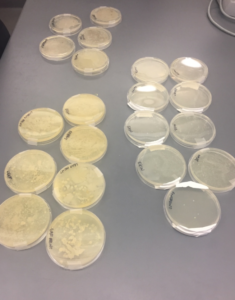

Dear Parents,
We were very excited today for Microbe Day! We taught the kids all about microbes in the world around us and how they fit into the larger ecosystem. They learned about microbial myths and facts, characteristics of microbes, and their applications. They also learned how to look at microbial plates under the microscope and how to distinguish the bacteria from each other. Our fearless students went outside to pick up as many microbes as they could on their hands to make a microbial handprint on an agar plate (like the one here). We promise they washed their hands afterwards and we can’t wait to see what microbes grew from their handprints!
They also learned about experimental design and put claims of Bounty paper towels being more absorbent than generic towels to the test. They used this experience to design their own microbial experiment with the proper controls and treatment groups. They’ll collect and analyze their data later this week. We finished the day by discussing concerns about antibiotic resistance in the environment. We played a game that demonstrated how antibiotic-resistant bacteria can grow and spread and held a case study where we discussed policies for regulating antibiotic use in the environment. Ask your kids about their experimental setup! We’re excited to see the results. You could also talk to them about the microbes they built- what is the function of each part of their microbe?
If any of the kids are interested in microbial citizen science, show this to their science teacher and ask about bringing the Wolbachia Project to their classroom! For more information, click here.
Get excited about aquatic ecosystems for tomorrow!
-The Microbe Team (Teddy and Jessie)
Creating Our Own Experiments